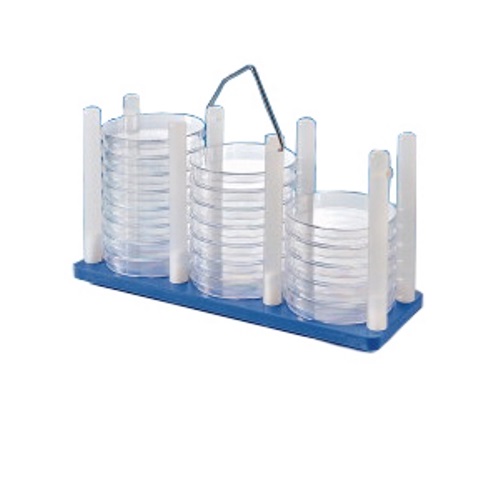
Szalki Petriego

A-Z
Adaptery do strzykawek
Adaptery szklane do szlifów
Akcesoria do łaźni
Akcesoria do mieszadeł magnetycznych
Akcesoria do mikserów, młynków i homogenizatorów
Akcesoria do myjek ultradźwiękowych
Akcesoria do palników
Akcesoria do palników
Akcesoria do termometrów, higrometrów i pirometrów
Akcesoria do vorteksów
Akcesoria do wag laboratoryjnych
Akcesoria do ważenia
Akcesoria do wirówek
Akcesoria do wytrząsarek platformowych
Akumulatory
Ampułki szklane
Aparaty do destylacji
Aparaty do elektroforezy i akcesoria
Artykuły z krótkim terminem ważności
Bagietki do mieszadełek
Bagietki i łopatki do mieszania
Bagietki i łopatki plastikowe
Bagietki szklane
Bagietki, głaszczki, łyżeczki szklane
Barwiacze i komory na szkiełka
Barwiacze szklane na szkiełka mikroskopowe
Baterie
Beczki plastikowe
Beczki plastikowe
Bez kategorii
Biologia molekularna - Jena Bioscience
Biurety
Biurety plastikowe
Biurety szklane
Bloki aluminiowe
Butelki
Butelki
Butelki do hodowli
Butelki do hodowli plastikowe
Butelki do hodowli szklane
Butelki do pożywek
Butelki do pożywek plastikowe
Butelki do pożywek szklane
Butelki metalowe
Butelki plastikowe
Butelki plastikowe do wirówek
Butelki plastikowe i zamknięcia
Butelki plastikowe z gwintem
Butelki plastikowe z gwintem
Butelki plastikowe z szeroką szyją
Butelki plastikowe z szeroką szyją
Butelki plastikowe z wąską szyją
Butelki plastikowe z wąską szyją
Butelki szklane
Butelki szklane i zamknięcia
Butelki szklane z gwintem
Butelki szklane z gwintem
Butelki szklane ze szlifem
Butelki szklane ze szlifem
Butelki, probówki, kolby do hodowli
Butle plastikowe
Butle plastikowe
Chłodnice szklane
Chusteczki i ściereczki do czyszczenia i konserwacji sprzętu
Cylindry miarowe
Cylindry miarowe plastikowe
Cylindry miarowe szklane
Cylindry Nesslera szklane
Cylindry niskie szklane
Cylindry wysokie szklane
Cylindry, kolby, zlewki
Czasomierze, stopery
Czasomierze, zegary
Czasze grzejne
Czepki, nabrodniki
Czerpaki
Czerpaki, próbniki, sondy
Części i akcesoria do aparatury laboratoryjnej
Czujniki temperaturowe
Czyściwa, ręczniki
Densytometry
Densytometry
Densytometry
Destylarki szklane
Dezynfekcja, czyszczenie, utylizacja
Do ciekłego azotu
Do suchego lodu
Dozowniki butelkowe
Dozowniki strzykawkowe (steppery)
Drabinki
Drukarki do etykiet
Druty metalowe
Druty metalowe
Ekstraktory szklane
Eksykatory plastikowe i akcesoria
Eksykatory plastikowe w zestawach
Eksykatory szklane i akcesoria
Eksykatory szklane w zestawach
Elektrody do pomiaru pH
Elektrody i akcesoria
Emitery światła
Enzymy
Ezy, igły mikrobiologiczne
Ezy, igły, głaszczki, druty
Fartuchy
Fartuchy, kombinezony, zarękawniki
Filtracja
Filtry bibułowe
Filtry do masek
Filtry strzykawkowe
Filtry wirówkowe
Filtry z włókna szklanego
Filtry, filtry strzykawkowe i strzykawki
Filtry, sączki, gilzy ekstrakcyjne
Fiolki i zamknięcia
Fiolki o poj. 2,5-6 ml
Fiolki o poj. 20-100 ml
Fiolki o poj. 6,5-18 ml
Fiolki o poj. do 2 ml
Fiolki wg pojemności
Fiolki wg typu zamknięcia
Fiolki z kapslami
Fiolki z kapslami - kołnierz ND10
Fiolki z kapslami - kołnierz ND11
Fiolki z kapslami - kołnierz ND13
Fiolki z kapslami - kołnierz ND20
Fiolki z kapslami - kołnierz ND32
Fiolki z kapslami - kołnierz ND8
Fiolki z kapslami - kołnierz ND9
Fiolki z nakrętkami
Fiolki z nakrętkami - gwint ND10
Fiolki z nakrętkami - gwint ND11
Fiolki z nakrętkami - gwint ND13
Fiolki z nakrętkami - gwint ND15
Fiolki z nakrętkami - gwint ND18
Fiolki z nakrętkami - gwint ND20
Fiolki z nakrętkami - gwint ND24
Fiolki z nakrętkami - gwint ND8
Fiolki z nakrętkami - gwint ND9
Fiolki z zatyczkami
Fiolki z zatyczkami - kołnierz ND11
Fiolki z zatyczkami - kołnierz ND18
Fiolki z zatyczkami - kołnierz ND22
Fiolki, ampułki, zamknięcia do fiolek
Folie aluminiowe
Folie aluminiowe
Folie do zgrzewarek
Folie z tworzyw sztucznych
Folie z tworzyw sztucznych
Folie, parafilmy, taśmy uszczelniające
Folie, parafilmy, taśmy uszczelniające
Higrometry elektroniczne
Homogenizatory elektryczne
Homogenizatory ręczne
Homogenizatory ręczne metalowe
Homogenizatory ręczne plastikowe
Homogenizatory ręczne szklane
Homogenizatory szklane
Igły
Igły i strzykawki
Igły preparacyjne
Igły preparacyjne
Inkubatory
Inne naczynia do hodowli
Inserty do fiolek
Izolacja genomowego DNA z bakterii
Izolacja genomowego DNA z krwi
Izolacja genomowego DNA z prób kryminalistycznych
Izolacja genomowego DNA z roślin, grzybów, żywności lub gleby
Izolacja genomowego DNA z tkanek
Izolacja i oczyszczanie DNA, RNA i białek - Macherey-Nagel
Izolacja plazmidowego DNA
Izolacja RNA
Izolacja wirusowego DNA
Kamyki i pręciki wrzenne
Kanistry plastikowe
Kanistry plastikowe
Kanistry, butle, beczki
Kanistry, butle, beczki
Kapilarne
Kapsle do fiolek
Kapslownice
Kapslownice
Kartonowe
Kasetki histologiczne
Kasety rentgenowskie
Klamry i mankiety do szlifów
Klamry i mankiety do szlifów
Kleje, spraye, smary, wazeliny
Klipsy zamykające do membran
Klipsy zamykające do membran
Klipsy, zaciski, zamknięcia
Klucze, śrubokręty, korkobory, narzędzia
Kolby do hodowli
Kolby do hodowli plastikowe
Kolby do hodowli szklane
Kolby Erlenmeyera (stożkowe) plastikowe
Kolby Erlenmeyera (stożkowe) szklane
Kolby filtracyjne
Kolby filtracyjne szklane
Kolby miarowe
Kolby miarowe plastikowe
Kolby miarowe szklane
Kolby okrągłodenne, płaskodenne, szpiczaste szklane
Kolby szklane
Kolby, cylindry, zlewki
Kolektory frakcji
Kolumny chromatograficzne
Kolumny i płytki do chromatografii
Kolumny szklane
Kolumny, chłodnice, ekstraktory, destylarki
Kombinezony, spodnie, zarękawniki
Końcówki bez filtra o poj. 100-500 µl
Końcówki bez filtra o poj. 100-500 µl
Końcówki bez filtra o poj. 1000-1500 µl
Końcówki bez filtra o poj. 1000-1500 µl
Końcówki bez filtra o poj. 2,5-10 ml
Końcówki bez filtra o poj. 2,5-10 ml
Końcówki bez filtra o poj. do 50 µl
Końcówki bez filtra o poj. do 50 µl
Końcówki Biozym o poj. 100-500 µl
Końcówki Biozym o poj. 1000-1500 µl
Końcówki Biozym o poj. 2,5-10 ml
Końcówki Biozym o poj. do 50 µl
Końcówki do dozowników strzykawkowych (stepperów)
Końcówki do dozowników strzykawkowych (stepperów)
Końcówki do pipet
Końcówki do pipet
Końcówki do pipet AHN
Końcówki do pipet AHN
Końcówki do pipet Biozym
Końcówki do pipet Biozym
Końcówki do pipet Brand
Końcówki do pipet Brand
Końcówki do pipet Eppendorf
Końcówki do pipet Eppendorf
Końcówki do pipet Gilson
Końcówki do pipet Gilson
Końcówki do pipet HTL
Końcówki do pipet HTL
Końcówki do pipet innych producentów
Końcówki do pipet innych producentów
Końcówki do pipet Interscience
Końcówki do pipet Interscience
Końcówki do pipet Sarstedt
Końcówki do pipet Sarstedt
Końcówki do pipet Sartorius Biohit
Końcówki do pipet Sartorius Biohit
Końcówki do pipet Socorex
Końcówki do pipet Socorex
Końcówki do pipet Sorenson
Końcówki do pipet Sorenson
Końcówki do pipet Thermo Scientific
Końcówki do pipet Thermo Scientific
Końcówki do systemów automatycznych
Końcówki do systemów automatycznych
Końcówki wg pojemności - bez filtra
Końcówki wg pojemności - bez filtra
Końcówki wg pojemności - z filtrem
Końcówki wg pojemności - z filtrem
Końcówki wg producentów
Końcówki wg producentów
Końcówki z filtrem o poj. 100-500 µl
Końcówki z filtrem o poj. 100-500 µl
Końcówki z filtrem o poj. 1000-1500 µl
Końcówki z filtrem o poj. 1000-1500 µl
Końcówki z filtrem o poj. 2,5-10 ml
Końcówki z filtrem o poj. 2,5-10 ml
Końcówki z filtrem o poj. do 50 µl
Końcówki z filtrem o poj. do 50 µl
Konduktometry, tlenomierze
Korki plastikowe ze szlifem
Korki plastikowe ze szlifem
Korki szklane
Korki ze szlifem
Korki ze szlifem do butelek
Korki, kapsle, zamknięcia do kolb i probówek
Korki, kapsle, zamknięcia do kolb i probówek
Kosze
Kosze do sterylizacji
Kosze, nosidła, wiadra
Kraniki do węży
Kraniki, zakrętki do eksykatorów
Kraniki, zakrętki do eksykatorów
Kraniki, zakrętki do kanistrów, butli i beczek
Kraniki, zakrętki do kanistrów, butli i beczek
Krioprobówki
Kriopudełka
Kroplomierze, dozowniki
Kroplomierze, dozowniki plastikowe
Kroplomierze, dozowniki plastikowe
Kroplomierze, dozowniki szklane
Kroplomierze, dozowniki szklane
Kroplomierze, rozpylacze szklane
Kroplomierze, rozpylacze, dozowniki plastikowe
Krystalizatory
Krystalizatory
Krystalizatory, parownice, tygle, moździerze
Krystalizatory, parownice, tygle, moździerze
Krzesła, taborety
Krzesła, taborety, podpórki, drabinki
Kubki na próbki
Kubki plastikowe na próbki
Kuchenki mikrofalowe
Kuchenki mikrofalowe, suszarki
Kuwety laboratoryjne
Kuwety spektrofotometryczne
Kuwety spektrofotometryczne plastikowe
Kuwety spektrofotometryczne plastikowe
Kuwety spektrofotometryczne szklane i kwarcowe
Kuwety spektrofotometryczne szklane i kwarcowe
Kuwety, miski, tace, wanienki
Lampy na podczerwień
Lampy podstawowe
Lampy UV
Lampy, latarki, emitery, płyty podświetlane
Lampy, przyrządy optyczne, artykuły do mikroskopii
Latarki
Lejki Büchnera
Lejki Büchnera szklane i porcelanowe
Lejki i kolby filtracyjne
Lejki i tygle ze spiekiem szklane
Lejki plastikowe
Lejki podstawowe szklane
Lejki stalowe
Lejki szklane
Lejki ze spiekiem
Lejki, naczynia sedymentacyjne
Lejki, stożki sedymentacyjne plastikowe
Liczniki kolonii bakterii i komórek
Liczniki, kalkulatory
Listwy, przedłużacze
Lupy
Lupy bez podświetlenia
Lupy z podświetleniem
Łączniki do węży
Łączniki, kraniki, zaciski i noże do węży
Ładowarki do akumulatorów
Łaźnie chłodzące
Łaźnie laboratoryjne
Łaźnie olejowe
Łaźnie wodne
Łyżeczki
Łyżeczki
Łyżeczki szklane
Mankiety, klamry, uszczelki do szlifów
Manometry
Manometry
Markery, pisaki, grawery
Maski pełne
Maski, filtry
Maty i folie uszczelniające do płytek
Maty i folie uszczelniające do płytek
Maty wchłaniające, ochronne, podłogowe, stołowe
Membrany do dializy
Membrany do dializy i akcesoria
Membrany, akcesoria do blottingu
Mierniki poziomu dźwięku
Mieszadełka magnetyczne (dipole)
Mieszadełka magnetyczne (dipole) i bagietki
Mieszadła magnetyczne bez grzania
Mieszadła magnetyczne i akcesoria
Mieszadła magnetyczne z grzaniem
Mieszadła mechaniczne
Mieszadła mechaniczne i akcesoria
Mieszanie, wytrząsanie, homogenizacja
Mikrobiologia, hodowla tkankowa
Mikroskopia, optyka, oświetlenie
Mikroskopy
Miksery
Miksery, homogenizatory
Miksery, młynki, homogenizatory elektryczne
Miniwirówki
Miski laboratoryjne
Młynki laboratoryjne
Moździerze i tłuczki
Moździerze i tłuczki
Myjki ultradźwiękowe
Myjki ultradźwiękowe
Na probówki o poj. 1,2-2,0 ml
Na probówki o poj. powyżej 2,0 ml
Na probówki PCR o poj. 0,2-0,6 ml
Naboje do palników
Naboje do palników
Naczynia Dewara
Naczynka wagowe szklane
Naczynka wagowe, piknometry
Naczynka, papier, szalki wagowe
Naklejki ostrzegawcze, informacyjne
Naklejki, etykiety
Naklejki, etykiety
Narzędzia i materiały pomocnicze
Narzędzia preparacyjne, olejki immersyjne, inne akcesoria do mikroskopii
Nasadki, adaptery, złączki szklane
Nauszniki, zatyczki do uszu
new category
Nosidła
nowa kategoriaaa
Noże, nożyczki, skalpele, ostrza, narz. preparacyjne
Nukleozydy, nukleotydy i ich modyfikacje - Biolog
Obcinaki do węży
Obuwie ochronne
Obuwie ochronne, ochraniacze na buty
Ochraniacze na buty
Ochrona i bezpieczeństwo pracy
Oczyszczanie białek
Oczyszczanie DNA
Odczynniki
Odczynniki
Odczynniki innych producentów
Odważniki i wzorce mas
Ogrzewanie, chłodzenie, mrożenie
Okulary ochronne
Okulary, wizjery, ekrany ochronne
Oleje do łaźni i termostatów
Otwieracze do ampułek i butelek
Otwieracze i klipsy zamykające do probówek
Otwieracze i klipsy zamykające do probówek
Oznaczanie i opisywanie
Palniki elektroniczne
Palniki elektroniczne
Palniki podstawowe
Palniki podstawowe
Palniki, płyty i bloki grzejne, mieszadła
Palniki, wyżarzarki, zapalarki
Palniki, wyżarzarki, zapalarki
Papier filtracyjny
Papierki do oznaczeń ilościowych
Papierki do oznaczeń jakościowych
Papierki do pomiaru obecności i stężenia jonów
Papierki do pomiaru pH
Papierki do pomiaru temperatury i wilgotności
Papierki wskaźnikowe
Parafilmy, taśmy uszczelniające
Parafilmy, taśmy uszczelniające
Parownice
Parownice
Pędzelki wagowe
Pędzle, pałeczki czyszczące
pH-metry, mierniki potencjału redox
Pierścienie obciążające i podstawki do kolb
Pierwsza pomoc
Piknometry szklane
Piknometry, areometry
Pincety
Pipetory
Pipetowanie, dozowanie
Pipety automatyczne
Pipety Brand
Pipety Eppendorf
Pipety Gilson
Pipety HTL
Pipety IKA
Pipety innych producentów
Pipety Interscience
Pipety jednomiarowe plastikowe
Pipety jednomiarowe szklane
Pipety kapilarne szklane
Pipety miarowe
Pipety neoLab
Pipety Pasteura
Pipety Pasteura plastikowe
Pipety Pasteura plastikowe
Pipety Pasteura szklane
Pipety Pasteura szklane
Pipety plastikowe
Pipety Sarstedt
Pipety Sartorius Biohit
Pipety Socorex
Pipety strzykawkowe
Pipety strzykawkowe plastikowe
Pipety SunLab
Pipety szklane
Pipety Thermo Scientific
Pipety wielomiarowe szklane
Pipety wielomiarowe, serologiczne plastikowe
Pipety zanurzeniowe szklane
Pipety, końcówki do pipet, kapilary
Pirometry
Plastiki laboratoryjne
Płuczki do gazów szklane
Płuczki do płytek
Płuczki do płytek
Płyny i proszki do czyszczenia i dezynfekcji sprzętu
Płyny ochronne do łaźni, termostatów i pomp
Płyny ochronne do pomp
Płytki do chromatografii
Płytki do eksykatorów
Płytki do eksykatorów
Płytki do hodowli
Płytki do hodowli
Płytki do PCR
Płytki mikrolitrowe, testowe, folie uszczelniające
Płytki testowe
Płytki testowe
Płytki testowe i do chromatografii, folie do płytek
Płytki testowe, hodowlane, folie uszczelniające
Płyty grzejne
Płyty i czasze grzejne
Płyty podświetlane
Podnośniki laboratoryjne
Podpórki
Podstawy do eksykatorów
Pojemniki chłodzące na probówki
Pojemniki do przechowywania art. BHP
Pojemniki do zamrażania na probówki
Pojemniki dozujące na art. czyszczące
Pojemniki i uchwyty na art. ochronne
Pojemniki na drobne produkty
Pojemniki na odczynniki do pipet wielokanałowych
Pojemniki na odczynniki do pipet wielokanałowych
Pojemniki na próbki, kubki
Pojemniki plastikowe na próbki
Pojemniki plastikowe z zakrętką na próbki
Pojemniki plastikowe z zatyczką na próbki
Pojemniki szklane
Pojemniki z zakrętką na próbki
Pojemniki z zatyczką na próbki
Pokrywy, uszczelki do eksykatorów
Półmaski
Pompy elektryczne
Pompy membranowe
Pompy perystaltyczne i dozujące
Pompy ręczne do zbiorników
Pompy, węże i akcesoria
Pozostałe fiolki z kapslami
Pozostałe fiolki z nakrętkami
Pozostałe fiolki z zatyczkami
Pozostałe przyrządy pomiarowe
Pręty i końcówki mieszające metalowe
Pręty i końcówki mieszające szklane
Pręty i końcówki mieszające szklane
Próbniki, sondy
Probówki
Probówki do hodowli
Probówki do hodowli plastikowe
Probówki do hodowli szklane
Probówki do PCR w paskach (stripach)
Probówki do PCR w paskach (stripach)
Probówki i butelki wirówkowe
Probówki plastikowe
Probówki plastikowe
Probówki plastikowe do wirówek
Probówki plastikowe o poj. 0,2-0,4 ml
Probówki plastikowe o poj. 0,2-0,4 ml
Probówki plastikowe o poj. 0,5-0,6 ml
Probówki plastikowe o poj. 0,5-0,6 ml
Probówki plastikowe o poj. 1,2-1,7 ml
Probówki plastikowe o poj. 1,2-1,7 ml
Probówki plastikowe o poj. 14-85 ml
Probówki plastikowe o poj. 14-85 ml
Probówki plastikowe o poj. 2,0 ml
Probówki plastikowe o poj. 2,0 ml
Probówki plastikowe o poj. 3,0-13 ml
Probówki plastikowe o poj. 3,0-13 ml
Probówki szklane
Probówki szklane
Probówki szklane do NMR
Probówki szklane do NMR
Probówki szklane do wirówek
Probówki szklane do wirówek
Probówki szklane do wirówek
Probówki szklane podstawowe
Probówki szklane podstawowe
Probówki szklane z zakrętkami
Probówki szklane z zakrętkami
Probówki szklane ze szlifem
Probówki szklane ze szlifem
Probówki, korki do probówek
Probówko-strzykawki
Produkty czyszczące
Produkty dezynfekujące
Produkty do usuwania DNA i RNA
Produkty neutralizujące
Próżniowe systemy do sączenia
Prysznice i płuczki laboratoryjne
Przechowywanie, pobór prób, transport
Przyłbice, wizjery, ekrany ochronne
Pudełka i statywy na fiolki
Pudełka kartonowe na probówki
Pudełka na fiolki
Pudełka na fiolki
Pudełka na fiolki
Pudełka na końcówki do pipet
Pudełka na końcówki do pipet
Pudełka na końcówki do pipet
Pudełka na kuwety spektrofotometryczne
Pudełka na kuwety spektrofotometryczne
Pudełka na kuwety spektrofotometryczne
Pudełka na probówki, fiolki, kuwety
Pudełka na probówki, fiolki, kuwety
Pudełka ochronne, skrzynie transportowe
Pudełka plastikowe na probówki o poj. 1,2-2,0 ml
Pudełka plastikowe na probówki o poj. 1,2-2,0 ml
Pudełka plastikowe na probówki o poj. 3,0-50 ml
Pudełka plastikowe na probówki o poj. 3,0-50 ml
Pudełka plastikowe na probówki PCR o poj. 0,2-0,6 ml
Pudełka plastikowe na probówki PCR o poj. 0,2-0,6 ml
Pudełka, etui, magazynki na szkiełka
Pudełka, statywy, etui na szkiełka mikroskopowe
Puszki, tubusy do sterylizacji
Reaktory
Reaktory szklane
Refraktometry
Refraktometry elektroniczne
Refraktometry ręczne
Refraktometry stołowe
Rejestratory
Rękawice jednorazowe
Rękawice jednorazowe lateksowe
Rękawice jednorazowe nitrylowe
Rękawice jednorazowe polietylenowe
Rękawice jednorazowe winylowe
Rękawice odporne na niskie temperatury
Rękawice odporne na przecięcia, przekłucia
Rękawice odporne na substancje żrące
Rękawice odporne na wysokie temperatury
Rękawice tekstylne, skórzane
Rękawice wielokrotnego użytku
Rękawiczki jednorazowe
Rotatory
Rozdzielacze szklane
Rozpylacze, spryskiwacze plastikowe
Rozpylacze, spryskiwacze szklane
Roztwory buforowe pH
Roztwory do miareczkowania
Roztwory do pomiaru przewodnictwa
Roztwory do przechowywania i czyszczenia elektrod
Roztwory do przechowywania i czyszczenia elektrod
Roztwory i bufory kalibracyjne
Sączki membranowe
Saszetki transportowe na szkiełka
Sita, sitka
Sita, tkaniny sitowe
Skrobaczki i szpatułki do kultur
Skrzynie transportowe
Smoczki i gruszki do pipet
Statywy do pipet automatycznych
Statywy do pipet Brand
Statywy do pipet Eppendorf
Statywy do pipet Gilson
Statywy do pipet HTL
Statywy do pipet innych producentów
Statywy do pipet Sartorius Biohit
Statywy do pipet Socorex
Statywy do pipet Thermo Scientific
Statywy do probówek hodowlanych
Statywy i butelki do elektrod
Statywy i dozowniki do folii, taśm i parafilmu
Statywy i dozowniki do folii, taśm i parafilmu
Statywy i nosidła na szalki Petriego
Statywy i pudełka na kuwety spektrofotometryczne
Statywy i uchwyty do mieszadeł
Statywy metalowe na probówki
Statywy na ezy
Statywy na fiolki
Statywy na fiolki
Statywy na fiolki
Statywy na kuwety spektrofotometryczne
Statywy na kuwety spektrofotometryczne
Statywy na kuwety spektrofotometryczne
Statywy na lejki i stożki sedymentacyjne
Statywy na probówki do łaźni wodnych
Statywy na probówki do łaźni wodnych
Statywy na probówki, fiolki, kuwety
Statywy na probówki, fiolki, kuwety
Statywy na szkiełka
Statywy na termometry, areometry, pipety, płytki, lejki
Statywy na termometry, areometry, pipety, płytki, lejki
Statywy plastikowe na probówki o poj. 1,2-2,0 ml
Statywy plastikowe na probówki o poj. 1,2-2,0 ml
Statywy plastikowe na probówki o poj. 3,0-50 ml
Statywy plastikowe na probówki o poj. 3,0-50 ml
Statywy plastikowe na probówki PCR o poj. 0,2-0,6 ml
Statywy plastikowe na probówki PCR o poj. 0,2-0,6 ml
Statywy, pręty, mufy, klamry
Statywy, pudełka, pojemniki
Stazy
Stazy
Stelaże do zamrażarek
Stelaże na kriopudełka
Sterylizatory, autoklawy
Sterylizatory, autoklawy
Stojaki i pojemniki na odpady
Stojaki, klipsy do worków
Stoły obrotowe, replikatory do płytek i szalek
Stomachery
Stomachery i akcesoria
Stożki sedymentacyjne
Stożki sedymentacyjne szklane
Strzykawki i igły
Strzykawki plastikowe
Strzykawki plastikowe
Strzykawki szklane
Styropianowe pojemniki transportowe
Suszarki
Suszarki i płyty ociekowe
Systemy odsysające
Systemy odsysające
Systemy odsysające i płuczki do płytek
Systemy odsysające i płuczki do płytek
Szafki, szuflady
Szalki aluminiowe
Szalki do hodowli
Szalki do hodowli plastikowe
Szalki Petriego
Szalki Petriego metalowe
Szalki Petriego plastikowe
Szalki Petriego plastikowe
Szalki Petriego szklane
Szalki Petriego szklane
Szalki Petriego, do hodowli, statywy na szalki
Szalki plastikowe
Szczotki laboratoryjne
Szczotki, pędzle, odkurzacze
Szczypce i chwytaki do gorących przedmiotów
Szczypce i chwytaki do gorących przedmiotów
Szkiełka mikroskopowe
Szkiełka mikroskopowe
Szkiełka mikroskopowe, nakrywkowe, zegarkowe
Szkiełka mikroskopowe, nakrywkowe, zegarkowe
Szkiełka nakrywkowe
Szkiełka nakrywkowe
Szkiełka z wgłębieniami
Szkiełka z wgłębieniami
Szkiełka zegarkowe
Szkiełka zegarkowe
Szkło i porcelana laboratoryjna
Szkło laboratoryjne
Szpatułki
Szpatułki
Szpatułki szklane
Szpatułki, łyżeczki, szufelki
Szpatułki, łyżeczki, szufelki
Szufelki
Szufelki
Szufelki i łopatki wagowe
Szuflady i pojemniki na drobne produkty
Środki czyszczące, worki i pojemniki na odpady
Środki do mycia i dezynfekcji skóry
Środki do pielęgnacji skóry
Środki ochrony osobistej
Tace laboratoryjne
Taśmy do sterylizacji
Taśmy i naklejki ostrzegawcze
Taśmy ostrzegawcze
Taśmy, statywy do taśm
Taśmy, wskaźniki, zapachy do sterylizacji
Termobloki
Termobloki, bloki aluminiowe
Termocyklery
Termometry
Termometry cieczowe, tarczowe
Termometry elektroniczne
Termometry, higrometry
Termomiksery
Termomiksery
Termomiksery
Termostaty i chłodnice cyrkulacyjne
Termosy, czajniki, automaty filtrujące
Testy diagnostyczne - Seratec
Testy diagnostyczne, zestawy testowe, odczynniki
Tkaniny sitowe
Torby izolacyjne i lodówki przenośne
Torebki i rękawy do sterylizacji
Tryskawki
Tryskawki
Tryskawki, cylindry, lejki, wiadra, kanistry
Tygle
Tygle
Uchwyty i lejki do membran
Uchwyty na pudełka z rękawiczkami
Uchwyty na pudełka z rękawiczkami
Urządzenia
Wagi analityczne
Wagi laboratoryjne
Wagi precyzyjne
Wagi przenośne i kompaktowe
Wagosuszarki
Wałki i inne urządzenia zamykające
Wałki i inne urządzenia zamykające
Wanienki do czyszczenia i sterylizacji
Wanienki do czyszczenia i sterylizacji
Wanienki i pojemniki na lód
Wanienki, puszki, kosze, torebki do sterylizacji
Wata, gaza, lignina
Wata, gaza, lignina
Ważenie, mierzenie, kontrola
Węże laboratoryjne
Wiadra
Wielomiarowe
Wirowanie, dializa, pompy
Wirówki
Wirówki stołowe
Wirówki z vorteksami
Wirówki z vorteksami
Wkłady i akcesoria do termobloków
Wkłady i akcesoria do termomikserów
Wkłady i minipoduszki chłodzące
Wkłady osuszające i perełki wskaźnikowe
Wkłady osuszające i perełki wskaźnikowe
Wkraplacze szklane
Woreczki na próbki - niesterylne
Woreczki na próbki - sterylne
Woreczki na próbki, zamknięcia
Worki i pojemniki na odpady
Worki na odpady
Worki na próbki do stomacherów
Wózki specjalne
Wózki transportowe
Wózki z półkami
Wózki z szufladami
Wskaźniki, etykiety do sterylizacji
Wyłączniki czasowe
Wymazówki
Wymazówki
Wymieniacze jonowe
Wyparki rotacyjne
Wyprzedaż
Wytrząsarki kołowe (orbitalne)
Wytrząsarki kołyskowe
Wytrząsarki liniowe (posuwisto-zwrotne)
Wytrząsarki platformowe
Wytrząsarki rolkowe
Wytwornice i kruszarki do lodu
Wyżarzarki do ez
Wyżarzarki do ez
Zabezpieczenie przed promieniowaniem β
Zaciski do węży
Zaciski do węży
Zakrętki do fiolek
Zakrętki i znaczniki do krioprobówek
Zakrętki i znaczniki do krioprobówek
Zakrętki, nasadki do butelek
Zakrętki, nasadki do butelek
Zakrętki, pierścienie, uszczelki do butelek
Zakrętki, pierścienie, uszczelki do butelek
Zamknięcia do woreczków
Zamknięcia do woreczków
Zamrażarki
Zapachy do autoklawów
Zapalarki
Zapalarki
Zasilacze
Zasilacze, ładowarki, baterie, akumulatory
Zatyczki i septy do fiolek
Zawory i filtry bezpieczeństwa
Zegary
Zestawy do filtracji plastikowe
Zestawy do filtracji plastikowe
Zestawy do filtracji szklane
Zestawy do filtracji szklane
Zgrzewarki
Zgrzewarki i folie do zgrzewarek
Zlewki
Zlewki niskie szklane
Zlewki Philipsa szklane
Zlewki plastikowe
Zlewki szklane
Zlewki wysokie szklane
Zlewki z uchwytem szklane i porcelanowe
Zmiotki, szufelki, odkurzacze